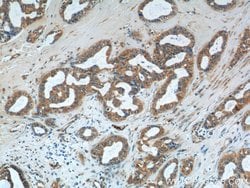
S100A9 Rabbit anti-Human, Mouse, Rat, Polyclonal, Proteintech 150 &mu;L;
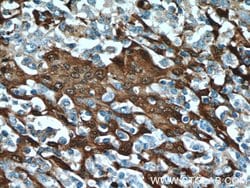
S100A9 Rabbit anti-Human, Mouse, Rat, Polyclonal, Proteintech 150 &mu;L;

missing translation for 'onlineSavingsMsg'
Learn More
Learn More
S100A9 Rabbit anti-Human, Mouse, Rat, Polyclonal, Proteintech
Rabbit Polyclonal Antibody
Brand: Proteintech 14226-1-AP-150UL
This item is not returnable.
View return policy
Description
S100A9 (MRP-14) is a member of the S100 family of proteins containing 2 EF-hand calcium-binding motifs. S100 proteins are localized in the cytoplasm and/or nucleus of a wide range of cells, and involved in the regulation of a number of cellular processes such as cell cycle progression and differentiation. S100 genes include at least 13 members which are located as a cluster on chromosome 1q21. This protein may function in the inhibition of casein kinase and altered expression of this protein is associated with the disease cystic fibrosis.Specifications
| S100A9 | |
| Polyclonal | |
| Unconjugated | |
| S100A9 | |
| 60B8AG, CAGB, Calgranulin B, Calprotectin L1H subunit, CFAG, CGLB, L1AG, LIAG, MAC387, MIF, MRP 14, MRP14, NIF, P14, Protein S100 A9, S100A9 | |
| Rabbit | |
| Antigen Affinity Chromatography | |
| RUO | |
| 20202, 6280, 94195 | |
| -20°C | |
| Liquid |
| Immunohistochemistry (Paraffin), Western Blot | |
| 0.19 mg/mL | |
| PBS with 50% glycerol and 0.02% sodium azide; pH 7.3 | |
| P06702, P31725, P50116 | |
| S100A9 | |
| S100A9 Fusion Protein Ag5465 | |
| 150 μL | |
| Primary | |
| Human, Mouse, Rat | |
| Antibody | |
| IgG |
Product Content Correction
Your input is important to us. Please complete this form to provide feedback related to the content on this product.
Product Title
Spot an opportunity for improvement?Share a Content Correction